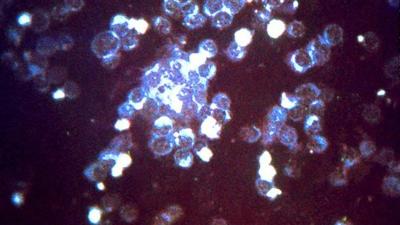
RSV

The Washoe County Health District is urging Nevadans to take precautions as RSV cases are surging this season.
“We are seeing a very strong uptick in RSV cases and we could be in for one of the worst RSV seasons that we've had in some time,” says Kevin Dick, Washoe County Health District Officer.
WCHD is reporting 156 RSV cases from last week, moving the total to 343 cases for this 2022-23 respiratory virus season, which started in early October. The 156 cases reported last week is more than the total number of cases reported during the first five weeks of the 2021-22 season (148 cases).
The Nevada Hospital Association is reporting increased RSV-related hospitalizations. Both pediatric hospital bed capacity and pediatric intensive care units (PICU) in Washoe County are at capacity or over capacity due to RSV, flu, COVID-19 and other respiratory viruses.
While most cases of RSV will go away on their own within a week or two, those most at risk for hospitalization are under 6 months of age (especially babies born prematurely) and older adults (especially those with chronic diseases).
Symptoms include a runny nose, decrease in appetite, coughing, sneezing, fever and wheezing.
While it may affect other ages less severely, the health district is asking those people still be cautious since it could pass to more vulnerable populations.
“Don't just take for granted if you have a cold or runny nose as no big deal. Please try to stay away from work and others until you get better to prevent the spread of disease in our community.”
Along with staying home when you’re sick, the health district also suggests washing your hands thoroughly for at least 20 seconds and cleaning common surfaces.
They also urge people to get their updated COVID boosters and flu shots.
(Washoe County Health District contributed to this report.)